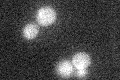
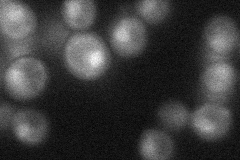
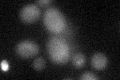

View description
Serine-rich protein that contains a basic-helix-loop-helix (bHLH) DNA binding motif; binds E-boxes of glycolytic genes and contributes to their activation; may function as a transcriptional activator in Ty1-mediated gene expression
Localization:
Intensity:
Fold change:
Significance:
-
C’ GFP library in SD
below threshold18.3 -
N' NOP1pr-GFP in SD
cytosol,nucleus33.6646 -
N' TEF2pr-mCherry in SD

below threshold7.44894 -
N' NATIVEpr-GFP in SD

punctate19.5594 -
N' TEF2pr-VC and Cyto-VN in SD

below threshold22.968 -
C’ GFP library in SD+DTT
cytosol17.740.96No -
C’ GFP library in SD+H2O2

cytosol170.92No -
C’ GFP library in Starvation Media

cytosol13.750.75No -
C’ GFP library on the background of Pup2-DaMP

below threshold -
C’ GFP library on the background of CCT mutant

below threshold18.17420.992388No
